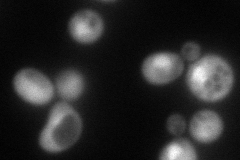
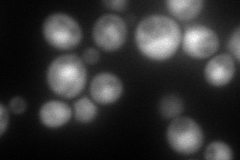
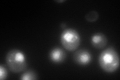

View description
Beta 2 subunit of the 20S proteasome; endopeptidase with trypsin-like activity that cleaves after basic residues; synthesized as a proprotein before being proteolytically processed for assembly into 20S particle; human homolog is subunit Z
Localization:
Intensity:
Fold change:
Significance:
-
C’ GFP library in SD

nucleus213.62 -
N' NOP1pr-GFP in SD
cytosol,nucleus132.941 -
N' TEF2pr-mCherry in SD
cytosol,nucleus149.713 -
N' NATIVEpr-GFP in SD

missing0 -
N' TEF2pr-VC and Cyto-VN in SD

cytosol38.3317 -
C’ GFP library in SD+DTT
nucleus241.31.12No -
C’ GFP library in SD+H2O2

nucleus244.41.14No -
C’ GFP library in Starvation Media

nucleus233.111.09No -
C’ GFP library on the background of Pup2-DaMP

nucleus -
C’ GFP library on the background of CCT mutant

nucleus230.9831.08126No
